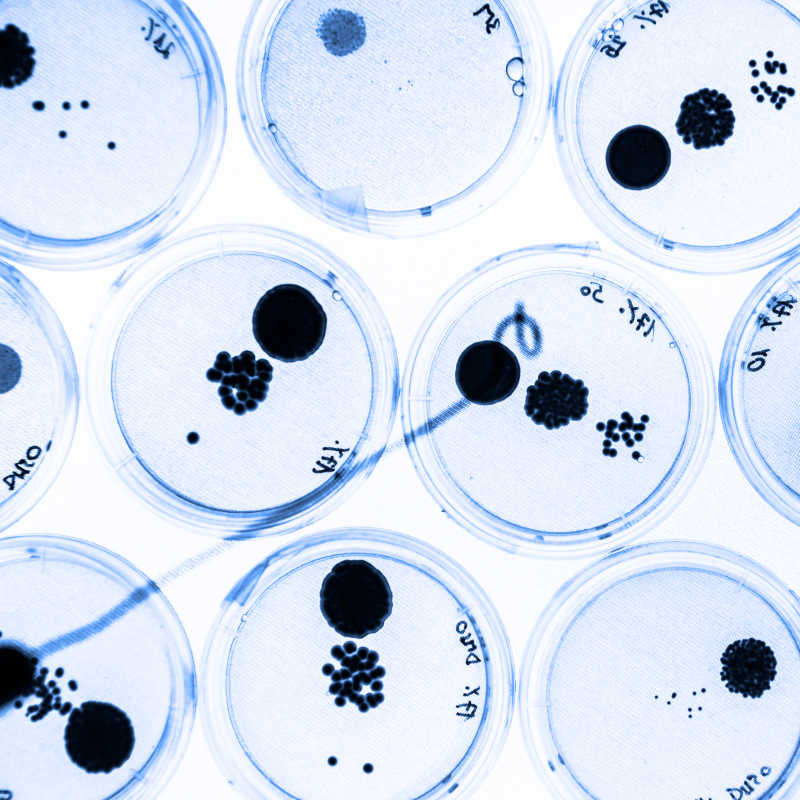
在琼脂培养皿中培养细菌作为科学实验的一部分

人类免疫系统在攻击病毒高清摄影图片。细菌也对人类活动有很大的影响。一方面,细菌是许多疾病的病原体,包括肺结核、淋病、炭疽病、梅毒、鼠疫、砂眼等疾病都是由细菌所引发。然而,人类也时常利用细菌,例如乳酪及酸奶和酒酿的制作、部分抗生素的制造、废水的处理等,都与细菌有关。在生物科技领域中,细菌有也著广泛的运用。
系列 一 显微镜下放大的细菌(40张图片)查看全部 >
标签
- 细菌
- 系统
- 细胞
- 病毒
- 动画
- 血
- 医疗
- 病菌
- 免疫学
- 巨蟹座
- 抗体
- 受体
- 白色
- 和
- 人造
- 生物学
- 身体
- 计算机
- 细胞质
- 数字
- 维度
- 文件
- 生成
- 图表
- 团队
- 医疗保健
- 中草药
- 高楼梯
- 人类
- 疾病
- 插图
- 图片
- 免疫
- 里面
- 环的准备
- 微距
- 巨噬细胞
- 放大
- 机制
- 医学
- 代谢
- 微型
- 微生物学
- 线粒体
- 模特
- 分子
- 物体
- 属于
- 有机体
- 渗透
- 红
- 提供
- 科学
- 形状
- 结构
- 物质
- 三
- 三维
- 可视化
- 世界
搜索
相似图片
X
收件人 :
时 间 :
发送